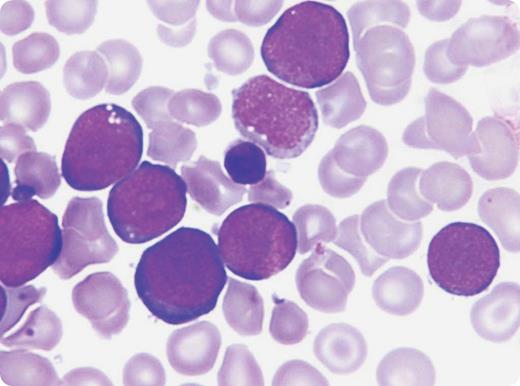
An 11-day-old boy presented with high-grade fever since the second day of life. He was dysmorphic with Down syndrome (DS) facies, pallor, irritability, tachypnea, pan-systolic murmur, and hepatosplenomegaly. Hemoglobin was 98 g/L, white cells were 254 × 109/L, and platelets were 31 × 109/L. Peripheral blood film (see figure) displayed 95% blast cells having deeply basophilic cytoplasm with blebs, multiple nucleoli, low platelets, and a few target cells. Liver enzymes and creatinine were normal. Circulating blasts were CD34+, CD36+, CD117+, CD13−, CD33−, and MPO−. Trisomy 21 was the sole cytogenetic abnormality. Supportive treatment was initiated. Leukapheresis and low-dose Ara-C were planned; however, the parents refused treatment and took the child out of the hospital. Transient myeloproliferative disorder (TMD) remained unresolved and the neonate soon succumbed to cardiorespiratory failure. / TMD was the presumed diagnosis because the child was a neonate with hepatomegaly and blasts with trisomy 21 with no other chromosomal abnormalities. TMD is a unique hematologic feature seen in 10% of neonates with DS. Its clinical, morphologic, and phenotypic features are indistinguishable from acute megakaryocytic leukemia (AMKL) but the blasts universally show trisomy 21 in TMD. Spontaneous remissions occur often but fatal forms are seen in 16% to 23% of cases.

An 11-day-old boy presented with high-grade fever since the second day of life. He was dysmorphic with Down syndrome (DS) facies, pallor, irritability, tachypnea, pan-systolic murmur, and hepatosplenomegaly. Hemoglobin was 98 g/L, white cells were 254 × 109/L, and platelets were 31 × 109/L. Peripheral blood film (see figure) displayed 95% blast cells having deeply basophilic cytoplasm with blebs, multiple nucleoli, low platelets, and a few target cells. Liver enzymes and creatinine were normal. Circulating blasts were CD34+, CD36+, CD117+, CD13−, CD33−, and MPO−. Trisomy 21 was the sole cytogenetic abnormality. Supportive treatment was initiated. Leukapheresis and low-dose Ara-C were planned; however, the parents refused treatment and took the child out of the hospital. Transient myeloproliferative disorder (TMD) remained unresolved and the neonate soon succumbed to cardiorespiratory failure.
TMD was the presumed diagnosis because the child was a neonate with hepatomegaly and blasts with trisomy 21 with no other chromosomal abnormalities. TMD is a unique hematologic feature seen in 10% of neonates with DS. Its clinical, morphologic, and phenotypic features are indistinguishable from acute megakaryocytic leukemia (AMKL) but the blasts universally show trisomy 21 in TMD. Spontaneous remissions occur often but fatal forms are seen in 16% to 23% of cases.
An 11-day-old boy presented with high-grade fever since the second day of life. He was dysmorphic with Down syndrome (DS) facies, pallor, irritability, tachypnea, pan-systolic murmur, and hepatosplenomegaly. Hemoglobin was 98 g/L, white cells were 254 × 109/L, and platelets were 31 × 109/L. Peripheral blood film (see figure) displayed 95% blast cells having deeply basophilic cytoplasm with blebs, multiple nucleoli, low platelets, and a few target cells. Liver enzymes and creatinine were normal. Circulating blasts were CD34+, CD36+, CD117+, CD13−, CD33−, and MPO−. Trisomy 21 was the sole cytogenetic abnormality. Supportive treatment was initiated. Leukapheresis and low-dose Ara-C were planned; however, the parents refused treatment and took the child out of the hospital. Transient myeloproliferative disorder (TMD) remained unresolved and the neonate soon succumbed to cardiorespiratory failure.
TMD was the presumed diagnosis because the child was a neonate with hepatomegaly and blasts with trisomy 21 with no other chromosomal abnormalities. TMD is a unique hematologic feature seen in 10% of neonates with DS. Its clinical, morphologic, and phenotypic features are indistinguishable from acute megakaryocytic leukemia (AMKL) but the blasts universally show trisomy 21 in TMD. Spontaneous remissions occur often but fatal forms are seen in 16% to 23% of cases.
For additional images, visit the ASH IMAGE BANK, a reference and teaching tool that iscontinually updated with new atlas and case study images. For more information visit http://imagebank.hematology.org.